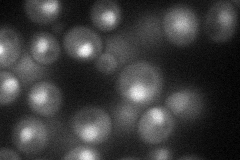
YGR002C
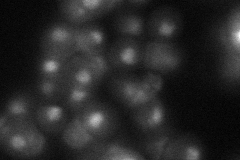
YGR002C
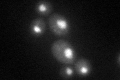
YGR002C

View description
Component of the Swr1p complex that incorporates Htz1p into chromatin; component of the NuA4 histone acetyltransferase complex
Localization:
Intensity:
Fold change:
Significance:
-
C’ GFP library in SD

nucleus28.83 -
N' NOP1pr-GFP in SD
cytosol,nucleus53.7538 -
N' TEF2pr-mCherry in SD
cytosol,nucleus58.4006 -
N' NATIVEpr-GFP in SD

nucleus28.7888 -
N' TEF2pr-VC and Cyto-VN in SD

punctate,nucleus26.4817 -
C’ GFP library in SD+DTT
nucleus30.151.04No -
C’ GFP library in SD+H2O2

nucleus24.720.85No -
C’ GFP library in Starvation Media

nucleus20.350.7Yes -
C’ GFP library on the background of Pup2-DaMP

nucleus -
C’ GFP library on the background of CCT mutant

nucleus36.87791.27895No
